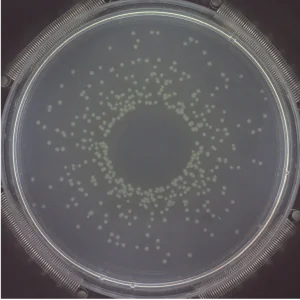

The Spiral Plater is a two-in-one method: it functions as both a diluter and a plater. The Spiral Plater saves time and waste throughout the inoculation process, which is why increasingly, more microbiological laboratories are opting to use Spiral Platers for bacterial determination.
Spiral Plating is an official methodology of the APHA, the AOAC, and recognized by the FDA BAM (Chapter 3). The process is as follows: Rapid plating inoculates a known volume of liquid sample on the surface of a rotating agar plate. As the dispensing syringe moves from the center of the plate to the edge of the rotating plate, the sample’s volume that is dispensed will decrease the Archimedean spiral.
Spiral Plating’s purpose creates serial dilutions on a single plate. By counting the colonies on a part of the Petri dish where they are easily countable then dividing this count by the appropriate volume, its microbial concentration may be determined.
The Eddy Jet, IUL’s rapid spiral plating device
Designed and manufactured by IUL Instruments, the Eddy Jet is a revolutionary approach to rapid plating. Its patented, unique system avoids cross-contamination through the use of proprietary micro syringes. This singular technology provides a very intuitive user interface without lengthy setup times.
Initially released in 1998, the first Eddy Jet’s sole purpose was to prevent any cross-contamination. In subsequent releases from IUL the improved Eddy Jet 2W spiral plater now includes its unique spiral spreader, which offers labs the highest sensitivity in the industry. Additionally, the Eddy Jet’s disposable tips, pre-sterilized via Electron Beam technology removes the need for cleaning cycles, thereby saving time.
Another superior Eddy Jet feature is the device’s dependable Stepper Microcontroller motors. These regulate the instrument’s high precision micro syringe liquid dispensing. This means that unlike other rapid plating devices, IUL’s approach eliminates cleaning cycle issues, disinfectant preparation, cross-contamination, unnecessary and complex liquid handling, or stylus calibration among others.
Eddy Jet Advantages
IUL’s Eddy Jet’s most important advantage is the amount of time and consumables that may be saved, such as when using Petri and solvent plates. Additionally, the Eddy Jet’s patented technology ensures that there will be no bleach residue to adversely affect sample bacteria, thereby avoiding false-negative results.
More than 25 spiral distributions such as a logarithmic, linear, and uniform distribution may be performed by the Eddy Jet. Each distribution type will correspond to a different pattern in the liquid sample as it spreads across the spiral. In short, this spiral plater will make a suitable rapid plating even for the most concentrated samples.

How a bacteria count in is performed using a spiral plater
Post their incubation, bacterial colonies will appear along the line of a spiral. If these colonies are sufficiently spaced from each other, researchers can count them on a special grid that associates a calibrated volume with each area. During this colony grid count, the sample volume becomes greater as the count begins at the outside edge of the plate and continues toward the center of the plate.
The speed by which the colony is counted may be increased by using an automatic colony counter such as the Sphere Flash. This spiral plating device features implemented methods to count different types of spreading colonies.
Spiral Plating Applications
Spiral plating, a rapid plating method, is widely used for credible microorganism enumeration in milk, cosmetics, and pharmaceuticals where a single spread’s detection range may be between 4.102 and 4.105 in the most useful and best showing of 50µl.
For more diluted samples the Eddy Jet can reach 1.102 to 1.105 using 200µl of the sample. While possible, it is not advisable. Should the agar not be sufficiently dry, it may contribute to the collapse of the spiral lines.
This spiral plating method is also used to test environmental water samples. Spiral platers are utilized in bio-pesticide challenges, frost prevention, and leaf studies in the agricultural and environmental industries. It also can be implemented for spiral MIC tests or mutagenicity assays, etc.